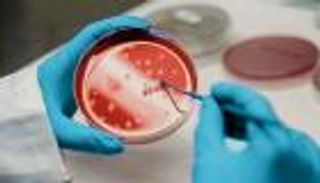
&laquo;أكثر أمانا وفاعلية&raquo;.. طفرة جديدة في علاجات الخلايا الجذعية

فك شفرة حوارات الخلايا.. ثورة في فهم المرض من الداخل

طور علماء أداتين حاسوبيتين قد تُحدثان تحولا في فهم كيفية تواصل الخلايا، وهي العملية الأساسية التي تحكم الصحة والمرض.
الأداتان الجديدتان، وهما "sCCIgen" و"QuadST" طورهما علماء من كلية ديوك-إن يو إس الطبية بسنغافورة، وتمكنان الباحثين لأول مرة من دراسة "حوارات الخلايا" بدقة غير مسبوقة، من خلال الجمع بين مواقع الخلايا داخل الأنسجة، ونشاطها الجيني، والإشارات الكيميائية التي تتبادلها في الحالات الطبيعية والمرضية.

أنسجة افتراضية لفهم التفاعل الخلوي
الأداة الأولى "sCCIgen"، التي نُشرت تفاصيلها في دورية"جينوم بيولوجي"، تُعد أول مُحاكٍ قادر على إنشاء أنسجة افتراضية واقعية متعددة الطبقات، تُظهر مواقع الخلايا، وأنماط نشاط الجينات، وشبكات التواصل بينها.
وتكمن أهميتها في أنها توفر ما يشبه "مختبرا تجريبيا آمنا” للعلماء، إذ تكون كل التفاعلات الخلوية معروفة سلفا، ما يسمح باختبار دقة الأدوات التحليلية قبل تطبيقها على بيانات حقيقية.
ويقول الأستاذ المشارك شياويو سونغ، الباحث الرئيسي في الدراستين بمركز الطب الكمي في كلية ديوك-إن يو إس الطبية بسنغافورة: "كما تمنح أجهزة محاكاة الطيران الطيارين بيئة آمنة للتدريب، تتيح الآداة (sCCIgen) للعلماء اختبار قدرتهم على رصد كيفية تواصل الخلايا بدقة، وهو ما سيسرع الاكتشافات في أبحاث السرطان والمناعة وعلوم الأعصاب".
فك شفرة التواصل الخلوي في الأنسجة الحقيقية
أما الأداة الثانية "QuadST" التي نُشرت تفاصيلها في دورية "جينوم ريسيرش"، فتركز على تحليل بيانات الأنسجة الحقيقية، وتكشف مباشرة عن الجينات التي يتغير نشاطها نتيجة تفاعل الخلايا مع جيرانها.
وعلى عكس الأساليب السابقة، تعتمد الأداة "QuadST" على تتبع التغير التدريجي في النشاط الجيني وفق المسافة بين أنواع الخلايا المختلفة، ما يجعلها أكثر دقة وقدرة على التعامل مع البيانات المعقدة أو غير المكتملة.
وعند تطبيق الأداة على أنسجة دماغية، تمكن الباحثون من تحديد مئات الجينات التي يتغير نشاطها عندما تتفاعل خلايا عصبية محددة، وترتبط العديد من هذه الجينات بوظائف المشابك العصبية، وهو ما قد يساعد في فهم اضطرابات مثل الصرع والأمراض التنكسية العصبية.
كما تتيح الأداة فهماً أعمق لتفاعل الخلايا السرطانية مع الجهاز المناعي، ولماذا يستجيب بعض المرضى للعلاج بشكل أفضل من غيرهم.

من الفهم إلى العلاج
ومن جانبه، أكد البروفيسور باتريك تان، نائب العميد الأول للبحث العلمي في الكلية أن الجمع بين الأداتين يوفر مسارا موثوقا لدراسة التواصل الخلوي، قائلًا: "يمكن للباحثين اختبار أدواتهم أولًا باستخدام أنسجة افتراضية عبر الأداة (sCCIgen)، ثم الانتقال لتحليل بيانات حقيقية باستخدام (QuadST) ما يعزز دقة النتائج ويساعد في اكتشاف آليات مرضية كانت خفية من قبل".
ويخطط الفريق البحثي لتوسيع قدرات "sCCIgen" لتشمل محاكاة البروتينات وتفاعلات جزيئية أخرى، إلى جانب استخدام "QuadST" لبناء قاعدة بيانات مرجعية للجينات المسؤولة عن التواصل الخلوي، بما يدعم تطوير علاجات أكثر دقة واستهدافا في المستقبل.